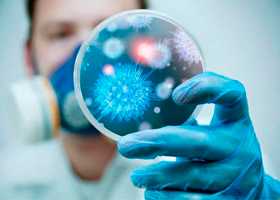
Внутрибольничные инфекции

Механизмы передачи внутрибольничных инфекций. Роль иммунизации в эпидемиологии.
Добавил пользователь Morpheus Обновлено: 17.12.2025
Медицинская микробиология:
Механизмы передачи внутрибольничных инфекций
Л.В. Громашевский, основоположник отечественной эпидемиологии, разработавший учение о механизме передачи инфекций — эволюционно сложившейся способности возбудителя к перемещению из одного организма в другой, тем самым обеспечивая сохранение возбудителя как биологического вида в природе, выделил 4 типа механизма передачи: воздушно-капельный, фекально-оральный, контактный и трансмиссивный.
Каждый из механизмов передачи соответствует определенной группе инфекций (дыхательных путей, кишечных инфекций, наружных покровов и кровяных). Механизм передачи инфекции связан с локализацией патологического процесса. Механизм передачи и локализация патологического процесса взаимосвязаны и взаимообусловлены. Например, при поражении дыхательных путей действует воздушно-капельный (аэрозольный) механизм передачи. При локализации патологического процесса в кишечнике реализуется фекально-оральный механизм передачи. Сложившееся в ходе эволюции взаимодействие локализации патологического процесса, связанного с ним механизма передачи и восприимчивого организма образуют эпидемический процесс. Непрерывность эпидемического процесса обеспечивает сохранение возбудителя (паразита) как биологического вида. Это фундаментальное положение сохраняет силу и поныне.
Однако названные механизмы передачи даже при дополнении их вертикальной передачей (заражение плода от матери во время внутриутробного развития) и заражением при прохождении через родовые пути матери, не исчерпывают всех возможностей инфицирования.
В современных условиях «поднял голову» новый мощный артифициальный механизм передачи, созданный как бы искусственно и связанный с инвазивными процедурами. Именно артифициальный (от лат. artificiale — искусственный) механизм передачи, возникший как побочный продукт медицины, играет важную роль в распространении внутрибольничных инфекций. Интенсификация артифициального механизма создала остроту проблемы ВБИ, возникающих у пациентов и медицинского персонала в связи с оказанием медицинской помощи в стационарах, амбулаторно-поликлинических условиях и на дому.
Артифициальный механизм передачи ассоциируется с широким спектром инвазивных диагностических и лечебных процедур, в редких случаях он связан с неинвазивными манипуляциями (ингаляционные процедуры).
Число инвазивных процедур и значимость артифициального механизма передачи в мире растет в связи с технизацией медицины, увеличением числа сложных диагностических и лечебных процедур и трудностью обеззараживания некоторых видов аппаратуры.
Действие артифициального механизма передачи может проявиться при различных манипуляциях, начиная от элементарных процедур (взятия крови, инъекций) и кончая сложнейшими операциями на жизненно важных органах, трансплантацией органов и тканей, в том числе искусственных органов.
Получение биоптатов органов и тканей, введение недостаточно обеззараженным шприцом различных препаратов таят в себе опасность инфицирования. Гемоконтактным путем может быть передано около 30 инфекций.
Опасность заражения существует при трансфузиях крови. Ежегодно в нашей стране вводится 7 млн доз крови и ее компонентов. При этом нельзя полностью исключить опасность заражения, поскольку в современных условиях кровь проверяется лишь на ограниченное число инфекций (ВИЧ-инфекция, гепатиты В, С, сифилис), причем применяемые методы детекции возбудителя ВИЧ-инфекции и гепатита С не совершенны.
По расчетным данным, в России за 1 год вследствие гемотрансфузий развивается:
• гепатит С — у 3500 человек;
• гепатит В — у 1400 человек;
• ВИЧ-инфекция — у 12 человек.
Стоимость лечения этих больных превышает 1334 млн долларов.
Учитывая эпидемическую опасность гемотрансфузии в стране, с нашим участием разработан специальный технический регламент к проекту Федерального закона «О требовании к безопасности гемотрансфузионных растворов, биокомпонентов и технических средств, используемых в инфузионной терапии». В этом регламенте предложены 2 позиции:
• необходимость обязательной проверки крови на ВИЧ-инфекцию и гепатит С при помощи высокочувствительных методов амплификации нуклеиновых кислот (NAAT-технологии), например определения рибонуклеиновой кислоты вируса в полимеразной цепной реакции (ПЦР). В большинстве стран Европы и США эти методы вошли в практику;
• применение карантинизации крови, хранение ее при -40°С с последующей проверкой донора через 6 месяцев.
Введение этих положений позволит свести к минимуму опасность заражения при гемотрансфузиях двумя наиболее опасными инфекциями, одна из которых пока полностью не излечима (ВИЧ-инфекция), а другая плохо поддается лечению и в 70-80% случаев обнаруживает наклонность к хронизации с развитием цирроза и гепатоцеллюлярной карциномы (гепатит С).
В дальнейшем введение лейкофильтрации, микрофильтрации, инактивации вирусов позволит предотвратить возможность заражения и другими инфекциями.
В медицине все шире применяются эндоскопические методы исследования. В зарубежной литературе, начиная с 70-х годов прошлого века, описано более 400 случаев инфицирования пациентов при проведении манипуляций гибкими эндоскопами. Клинические проявления инфекционного процесса варьировали от бессимптомного носительства до сепсиса, который заканчивался летальным исходом у нескольких десятков пациентов. Несмотря на высокую информативность, эффективность и малую травматичность, эндоскопические методы обследования и лечения могут приводить к заражению хеликобактериозом, туберкулезом, гепатитами В, С, D (скрытую кровь удавалось обнаружить азопирамовой пробой на наружной поверхности эндоскопической техники при отсутствии видимой травматизации слизистых оболочек и контакта с кровью). Надо помнить, что для обеспечения инфекционной безопасности количество выполняемых эндоскопических манипуляций должно соответствовать техническому оснащению, материальному и кадровому обеспечению эндоскопического подразделения ЛПУ. При ручном способе обработки кратность использования эндоскопа не должна превышать 4 раз за рабочую смену.
Нарушение противоэпидемического режима может приводить к возникновению ВБИ у пациентов и персонала при таких различных инвазивных вмешательствах, как стоматологические манипуляции (экстракция зубов, лечение пародонтоза) и внутривенная лазерная терапия, иглоукалывание и искусственное оплодотворение, примерка мостов при протезировании зубов и протезирование суставов. Заражение (хотя и много реже, чем при инвазивных процедурах) возможно при таких, казалось бы, «безобидных» манипуляциях, как ингаляции с целью лечения воспалительных процессов верхних дыхательных путей.
Интенсивное размножение грамотрицательных бактерий в жидких лекарственных формах, используемых в виде аэрозолей, создает иногда опасность инфицирования пациентов. Оснащение стационаров кондиционерами с увлажнителями при отсутствии должного контроля за их эксплуатацией может приводить к вспышкам легионеллеза. Быстрая адаптация легионелл к пластмассовым покрытиям таит в себе опасность инфицирования при приеме лечебного, веерного душа, особенно после застаивания воды в резервуаре.
Использование аппарата искусственной вентиляции легких, подчас спасая жизнь, увеличивает число ВБИ, особенно пневмоний.
При проведении мероприятий по разрыву механизма передачи важно предусмотреть меры по пресечению различных вариантов не только артифициального, но и естественного механизма передачи.
ВБИ, вызываемые условно-патогенными микроорганизмами, могут быть связаны как с экзогенным заражением (которое осуществляется преимущественно с реализацией искусственных путей передачи), так и эндогенным инфицированием, которое в ряде стационаров может преобладать над экзогенным.
Экзогенные инфекции нередко бывают связаны с реализацией как естественных путей передачи (пищевой, контактно-бытовой, воздушно-капельный, воздушно-пылевой др.), так и с искусственными путями, которые обычно при этом преобладают.
При эндогенных инфекциях заражение связано с собственной (нормальной, постоянной) микрофлорой пациента или флорой, приобретенной пациентом в ЛПУ и длительно колонизирующей этого пациента. Инфекция возникает в связи с действием факторов лечебно-диагностического процесса в том же биотопе или в других биотопах (транслокация). Примером может служить возникновение инфекции в области хирургического вмешательства при попадании в рану микроорганизмов, заселяющих кожу пациента или кишечник. Иногда возможны варианты эндогенного инфицирования, при котором происходит смена биотопов потенциальными возбудителями, когда его собственная флора переносится из одного участка организма в другой его собственными руками или руками медицинского персонала.
В лечебно-профилактических учреждениях могут активно действовать 3 из 4 типов естественного механизма передачи: воздушно-капельный, фекально-оральный, контактный. Трансмиссивный, связанный с живыми переносчиками, реализуется в современных условиях крайне редко. В эксквизитных условиях нельзя полностью исключить возможность передачи инфекции от пациента к пациенту через вшей, комаров и других насекомых. Известен факт внутрибольничной передачи сыпного тифа в психиатрическом стационаре.
Воздушно-капельный (аэрозольный) механизм передачи реализуется особенно легко во всех типах стационаров. (Понятия «механизм передачи» и «путь передачи» в данном случае тождественны, а воздух является конкретным фактором передачи.)
Воздушно-капельная передача приводит к распространению в разных типах стационаров стафилококковой, стрептококковой, клебсиеллезной инфекции, пневмоцистоза, легионеллеза, гриппа, острых респираторных вирусных инфекций и других заболеваний из группы инфекций дыхательных путей. Из числа инфекций дыхательных путей, управляемых средствами специфической профилактики, ликвидирована натуральная оспа в глобальных масштабах, другая инфекция — корь — практически ликвидирована, точнее находится на грани ликвидации. Снижена до спорадического уровня заболеваемость дифтерией, краснухой. Однако коклюш все еще беспокоит органы здравоохранения, поэтому заносы коклюша и паракоклюша в детские стационары вполне возможны.
Распространение кишечных инфекций связано с фекально-оральным механизмом передачи при действии пищевого, водного или контактно-бытового путей передачи. Наибольшим многообразием факторов передачи отличается пищевой путь. Вспышки кишечных инфекций в стационаре обычно являются результатом нарушения технологических процессов приготовления нищи на пищеблоке, изредка — использования продуктов, принесенных из дома. Дети, находящиеся на грудном вскармливании, могут инфицироваться при кормлении или докорме сцеженным молоком, при использовании недостаточно обработанного молокоотсоса, при наличии мастита у матери.
В возникновении внутрибольничных вспышек ротавирусных и норовирусных инфекций может быть повинно использование водопроводной воды, инфицированной на участке разводящей водопроводной сети. Реже действуют пищевой и контактно-бытовой пути передачи.
Важную роль в возникновении случаев внутрибольничного инфицирования играют руки. «Классические» кишечные инфекции (шигеллезы, сальмонеллезы, брюшной тиф) обычно вызывают групповые заболевания в психиатрических стационарах, домах престарелых, но госпитальные штаммы сальмонелл, особенно S. typhimurium и S. haifa, способны вызывать вспышки в стационарах разного типа, прежде всего в детских больницах, иногда в родовспомогательных учреждениях. Фактором передачи нередко служат руки персонала и пациентов.
Контактно-бытовым путем передаются эшерихии, энтерококки, эпидермальный стафилококк, госпитальные штаммы сальмонелл, ацинетобактеров и другие микроорганизмы. Фактором передачи могут стать белье, постельные принадлежности, поверхности предметов (ручки водопроводных кранов), руки персонала. На увлажненных объектах (поверхности раковин, влажная ветошь) способна размножаться синегнойная палочка, ацинетобактеры, серрации.
Говоря о естественных и искусственных путях передачи ВБИ, надо учитывать планировку больничных помещений, приемных, процедурных и диагностических кабинетов, палат, санитарно-гигиенические условия, соблюдение гигиенического режима работы персонала. Многие отечественные и зарубежные специалисты, а также руководитель Группы ВОЗ по глобальной безопасности пациентов Дидье Питтэ (Didier Pittet) подчеркивают, что гигиена рук является главной мерой для предупреждения инфекций, связанных с оказанием медицинской помощи, сокращения распространенности мультирезистентных микроорганизмов.
Подводя итог сказанному о механизмах передачи, следует еще раз подчеркнуть множественность механизмов передачи при ВБИ и особую значимость артифици-ального механизма передачи, связанного с «агрессией» инвазивных диагностических и лечебных процедур, в частности фактора грязных рук.
Что касается лиц, навещающих больных, то, как правило, они не играют существенной роли в распространении ВБИ.
Восприимчивость человека к ВБИ. Восприимчивость определяется рядом факторов:
• видовой восприимчивостью (как уже говорилось, человек восприимчив не ко всем зооантропонозам; к зоонозам практически не восприимчив, за редкими исключениями);
• индивидуальной характеристикой восприимчивости;
• фенотипичностью реакции, определяемой внутренними или внешними факторами (факторы риска);
• наличием иммунодефицитного состояния макроорганизма (приобретенного, врожденного).
Внутрибольничные инфекции не щадят ни одну возрастную группу населения. ВБИ могут поражать новорожденных детей, взрослых, лиц преклонного возраста. На двух «полюсах» жизни ВБИ встречаются чаще и протекают тяжелее в силу физиологической незрелости иммунитета (новорожденные) и постепенного его снижения (пожилые лица). Особенностей помесячного (в течение года) распределения заболеваний ВБИ не обнаруживается. Указания отдельных авторов на летнюю сезонность связаны с нарушением противоэпидемического режима в это время года. При четкой организации работы в лечебно-профилактическом учреждении различий в распределении ВБИ по месяцам не наблюдается.
На заболеваемость ВБИ влияет организация эпидемиологического надзора, выявление факторов риска, их учет при проведении профилактических и противоэпидемических мероприятий.
Внутрибольничные инфекции
Внутрибольничные инфекции - различные инфекционные заболевания, заражение которыми произошло в условиях лечебного учреждения. В зависимости от степени распространения различают генерализованные (бактериемию, септицемию, септикопиемию, бактериальный шок) и локализованные формы внутрибольничных инфекций (с поражением кожи и подкожной клетчатки, дыхательной, сердечно-сосудистой, урогенитальной системы, костей и суставов, ЦНС и т. д.). Выявление возбудителей внутрибольничных инфекций проводится с помощью методов лабораторной диагностики (микроскопических, микробиологических, серологических, молекулярно-биологических). При лечении внутрибольничных инфекций используются антибиотики, антисептики, иммуностимуляторы, физиотерапия, экстракорпоральная гемокоррекция и т. д.
Общие сведения
Внутрибольничные (госпитальные, нозокомиальные) инфекции - инфекционные заболевания различной этиологии, возникшие у пациента или медицинского сотрудника в связи с пребыванием в лечебно-профилактическом учреждении. Инфекция считается внутрибольничной, если она развилась не ранее 48 часов после поступления больного в стационар. Распространенность внутрибольничных инфекций (ВБИ) в медицинских учреждениях различного профиля составляет 5-12%. Наибольший удельный вес внутрибольничных инфекций приходится на акушерские и хирургические стационары (отделения реанимации, абдоминальной хирургии, травматологии, ожоговой травмы, урологии, гинекологии, отоларингологии, стоматологии, онкологии и др.). Внутрибольничные инфекции представляют собой большую медико-социальную проблему, поскольку утяжеляют течение основного заболевания, увеличивают длительность лечения в 1,5 раза, а количество летальных исходов - в 5 раз.

Этиология и эпидемиология внутрибольничных инфекций
Основными возбудителями внутрибольничных инфекций (85% от общего числа) выступают условно-патогенные микроорганизмы: грамположительные кокки (эпидермальный и золотистый стафилококк, бета-гемолитический стрептококк, пневмококк, энтерококк) и грамотрицательные палочковидные бактерии (клебсиеллы, эшерихии, энтеробактер, протей, псевдомонады и др.). Кроме этого, в этиологии внутрибольничных инфекций велика удельная роль вирусных возбудителей простого герпеса, аденовирусной инфекции, гриппа, парагриппа, цитомегалии, вирусных гепатитов, респираторно-синцитиальной инфекции, а также риновирусов, ротавирусов, энтеровирусов и пр. Также внутрибольничные инфекции могут быть вызваны условно-патогенными и патогенными грибами (дрожжеподобными, плесневыми, лучистыми). Особенностью внутригоспитальных штаммов условно-патогенных микроорганизмов служит их высокая изменчивость, лекарственная резистентность и устойчивость к воздействию факторов среды (ультрафиолета, дезинфектантов и пр.).
Источниками внутрибольничных инфекций в большинстве случаев выступают пациенты или медицинский персонал, являющиеся бактерионосителями или больными стертыми и манифестными формами патологии. Как показывают исследования, роль третьих лиц (в частности, посетителей стационаров) в распространении ВБИ невелика. Передача различных форм госпитальной инфекции реализуется с помощью воздушно-капельного, фекально-орального, контактного, трансмиссивного механизма. Кроме этого, возможен парентеральный путь передачи внутрибольничной инфекции при проведении различных инвазивных медицинских манипуляций: забора крови, инъекций, вакцинации, инструментальных манипуляций, операций, ИВЛ, гемодиализа и пр. Таким образом в медучреждении возможно заразиться гепатитами В, С и D, гнойно-воспалительными заболеваниями, сифилисом, ВИЧ-инфекцией. Известны случаи внутрибольничных вспышек легионеллеза при приеме больными лечебного душа и вихревых ванн.
Факторами, участвующими в распространении внутрибольничной инфекции, могут выступать контаминированные предметы ухода и обстановки, медицинский инструментарий и аппаратура, растворы для инфузионной терапии, спецодежда и руки медперсонала, изделия медицинского назначения многоразового использования (зонды, катетеры, эндоскопы), питьевая вода, постельные принадлежности, шовный и перевязочный материал и мн. др.
Значимость тех или иных видов внутрибольничной инфекции во многом зависит от профиля лечебного учреждения. Так, в ожоговых отделениях преобладает синегнойная инфекция, которая в основном передается через предметы ухода и руки персонала, а главным источником внутрибольничной инфекции являются сами пациенты. В учреждениях родовспоможения основную проблему представляет стафилококковая инфекция, распространяемая медицинским персоналом-носителем золотистого стафилококка. В урологических отделениях доминирует инфекция, вызываемая грамотрицательной флорой: кишечной, синегнойной палочкой и др. В педиатрических стационарах особую значимость имеет проблема распространения детских инфекций - ветряной оспы, эпидемического паротита, краснухи, кори. Возникновению и распространению внутрибольничной инфекции способствуют нарушение санитарно-эпидемиологического режима ЛПУ (несоблюдение личной гигиены, асептики и антисептики, режима дезинфекции и стерилизации, несвоевременное выявление и изоляция лиц-источников инфекции и т. д.).
К группе риска, в наибольшей степени подверженной развитию внутрибольничной инфекции, относятся новорожденные (особенно недоношенные) и дети раннего возраста; пожилые и ослабленные пациенты; лица, страдающие хроническими заболеваниями (сахарным диабетом, болезнями крови, почечной недостаточностью), иммунодефицитом, онкопатологией. Восприимчивость человека к внутрибольничным инфекциям увеличивается при наличии у него открытых ран, полостных дренажей, внутрисосудистых и мочевых катетеров, трахеостомы и других инвазивных устройств. На частоту возникновения и тяжесть течения внутрибольничной инфекции влияет долгое нахождение пациента в стационаре, длительная антибиотикотерапия, иммуносупрессивная терапия.
Классификация внутрибольничных инфекций
По длительности течения внутрибольничные инфекции делятся на острые, подострые и хронические; по тяжести клинических проявлений - на легкие, среднетяжелые и тяжелые формы. В зависимости от степени распространенности инфекционного процесса различают генерализованные и локализованные формы внутрибольничной инфекции. Генерализованные инфекции представлены бактериемией, септицемией, бактериальным шоком. В свою очередь, среди локализованных форм выделяют:
- инфекции кожи, слизистых и подкожной клетчатки, в т. ч. послеоперационных, ожоговых, травматических ран. В частности, к их числу относятся омфалит, абсцессы и флегмоны, пиодермия, рожа, мастит, парапроктит, грибковые инфекции кожи и др.
- инфекции полости рта (стоматит) и ЛОР-органов (ангина, фарингит, ларингит, эпиглоттит, ринит, синусит, отит, мастоидит)
- инфекции бронхолегочной системы (бронхит, пневмония, плеврит, абсцесс легкого, гангрена легкого, эмпиема плевры, медиастинит)
- инфекции пищеварительной системы (гастрит, энтерит, колит, вирусные гепатиты)
- глазные инфекции (блефарит, конъюнктивит, кератит)
- инфекции урогенитального тракта (бактериурия, уретрит, цистит, пиелонефрит, эндометрит, аднексит)
- инфекции костно-суставной системы (бурсит, артрит, остеомиелит)
- инфекции сердца и сосудов (перикардит, миокардит, эндокардит, тромбофлебиты).
- инфекции ЦНС (абсцесс мозга, менингит, миелит и др.).
Диагностика внутрибольничных инфекций
Критериями, позволяющими думать о развитии внутрибольничной инфекции, служат: возникновение клинических признаков заболевания не ранее чем через 48 часов после поступления в стационар; связь с проведением инвазивного вмешательства; установление источника инфекции и фактора передачи. Окончательное суждение о характере инфекционного процесса получают после идентификации штамма возбудителя с помощью лабораторных методов диагностики.
Для исключения или подтверждения бактериемии проводится бактериологический посев крови на стерильность, желательно не менее 2-3-х раз. При локализованных формах внутрибольничной инфекции микробиологическое выделение возбудителя может быть произведено из других биологических сред, в связи с чем выполняется посев мочи, кала, мокроты, отделяемого ран, материала из зева, мазка с конъюнктивы, из половых путей на микрофлору. Дополнительно к культуральному методу выявления возбудителей внутрибольничных инфекций используются микроскопия, серологические реакции (РСК, РА, ИФА, РИА), вирусологический, молекулярно-биологический (ПЦР) методы.
Лечение внутрибольничных инфекций
Сложности лечения внутрибольничной инфекции обусловлены ее развитием в ослабленном организме, на фоне основной патологии, а также резистентностью госпитальных штаммов к традиционной фармакотерапии. Больные с диагностированными инфекционными процессами подлежат изоляции; в отделении проводится тщательная текущая и заключительная дезинфекция. Выбор противомикробного препарата основывается на особенностях антибиотикограммы: при внутрибольничной инфекции, вызванной грамположительной флорой наиболее эффективен ванкомицин; грамотрицательными микроорганизмами - карбапенемы, цефалоспорины IV поколения, аминогликозиды. Возможно дополнительное применение специфических бактериофагов, иммуностимуляторов, интерферона, лейкоцитарной массы, витаминотерапии.
При необходимости проводится чрескожное облучение крови (ВЛОК, УФОК), экстракорпоральная гемокоррекция (гемосорбция, лимфосорбция). Симптоматическая терапия осуществляется с учетом клинической формы внутрибольничной инфекции с участием специалистов соответствующего профиля: хирургов, травматологов, пульмонологов, урологов, гинекологов и др.
Профилактика внутрибольничных инфекций
Основные меры профилактики внутрибольничных инфекций сводятся к соблюдению санитарно-гигиенических и противоэпидемических требований. В первую очередь, это касается режима дезинфекции помещений и предметов ухода, применения современных высокоэффективных антисептиков, проведения качественной предстерилизационной обработки и стерилизации инструментария, безукоснительного следования правилам асептики и антисептики.
Медицинский персонал должен соблюдать меры индивидуальной защиты при проведении инвазивных процедур: работать в резиновых перчатках, защитных очках и маске; осторожно обращаться с медицинским инструментарием. Большое значение в профилактике внутрибольничных инфекций имеет вакцинация медработников от гепатита В, краснухи, гриппа, дифтерии, столбняка и других инфекций. Все сотрудники ЛПУ подлежат регулярному плановому диспансерному обследованию, направленному на выявление носительства патогенов. Предупредить возникновение и распространение внутрибольничных инфекций позволит сокращение сроков госпитализации пациентов, рациональная антибиотикотерапия, обоснованность проведения инвазивных диагностических и лечебных процедур, эпидемиологический контроль в ЛПУ.
Внутрибольничные инфекции (ВБИ)
Распространение: Среди госпитализированных больных ВБИ встречаются за рубежом от 3 % до 21,4 % (в среднем у 8,4 %), в отделениях интенсивной терапии этот показатель возрастает до 20 -45 %. В нашей стране по данным официальной регистрации ежегодно выявляется 50 000 - 60 000 случаев ВБИ, в тоже время по расчетным данным их количество должно быть около 2,5 млн. случаев, т.е. 7 % среди госпитализированных больных. По данным ВОЗ в структуре ВБИ ведущее место занимают инфекции мочевыводящей системы (30-40 %), затем инфекции дыхательных путей (15-20 %) и инфекции в области хирургического вмешательства (15-17 %).
Степень опасности: Нарушения санитарно-гигиенического и противо-эпидемического режима в лечебных учреждениях (ЛПУ), которые чаще проявляется в ЧС, приводят к росту заболеваемости ВБИ. Наслаиваясь на травму, ожог, ради&активное или химическое поражение, инфекционное заболевание и др., ВБИ утяжеляют течение основного заболевания, увеличивают время лечения больного и могут приводить к летальным исходам.
Этиология: перечень возбудителей ВБИ включает представителей различных таксономических групп, относящихся к бактериям, вирусам, грибам, простейшим.
1. Бактерии представлены как аэробными так и анаэробными видами. Анаэробная инфекция, как правило, развивается за счет активизации эндогенной флоры макроорганизма при операциях и травмах кишечника, у онкологических больных. Встречается и экзогенное попадание возбудителей особенно во время травм и ранений, при проведении медицинских манипуляций. Аэробные бактериии, вызывающие ВБИ принадлежат, в основном, к условно-патогенным микроорганизмам и могут также являться представителями нор-
мальной микрофлоры организма человека. К ним относятся стафилококки (золотистый, эпидермальный, сапрофитический и др.), энтерококки, стрептококки, грамотрицательные бактериии семейства энтеробактерий (кишечная палочка, клебсиелла, протей, серрация, цитробактер и др.), псевдомонады, неферментирующиеся грамотрицательные бактерии и т.д. ВБИ, как правило, вызываются внутри-госпитальными штаммами (ВГШ) грамположительных и грамотри-цательных бактерий, которые приобрели ряд признаков, отличающих их от внегоспитальных штаммов. ВГШ адаптировались к существованию в стационарах, у них более высокая устойчивость по отношению к неблагоприятным факторам внешней среды - высушиванию, действию УФ-лучей, дезинфицирующих препаратов (при заниженных концентрациях дезинфектантов ВГШ могут не только сохраняться, но и размножаться в них). Множественная лекарственная устойчивость к антибиотикам и химиопрепаратам за счет наличия R-плазмиды, которая может передаваться от одной бактериальной клетки к другой. ВГШ способны преодолевать барьеры неспецифической резистентности организма. У них наблюдается исключительная пластичность метаболизма (могут сохраняться и размножаться на объектах окружающей среды, в растворах лекарственных препаратов). Для ВГШ характерна атропность к тканям (воспалительный процесс возникает в любой ткани выстилающий орган или в месте попадания или при гематогенном распространении). Этиологическими агентами ВБИ могут быть и патогенные бактерии (ши-геллы, коринебактерии, сальмонеллы и др.)
2. Вирусы - вызывают как спорадические заболевания, так и
вспышки. В стационарах регистрируются вирусные гепатиты А, В,
С, грипп и другие ОРВИ, энтеровирусные инфекции, ротавирусная
инфекция, цитомегалии, герпес, краснуха, корь и ряд других.
3. Грибы - в настоящее время возросла роль грибов в этио
логии ВБИ. Основное значение играют грибы рода Candida, регист
рируются также ВБИ вызванные аспергиллами, криптококками,
кокцидиоидами и др.
4. Паразитарные микро и макроорганизмы, простейшие -
криптоспоридии, плазмодии, чесоточный клещ, головная, платяная
и лобковая вошь.
Источник инфекции: больные с различными формами проявления инфекционного процесса от бессимптомного носительства и легких стертых форм, до тяжелых клинических форм, как среди пациентов, поступивших или находящихся в стационаре, так и сре-
ди медицинского персонала. Особенно велика роль медицинских работников в стационарах закрытого типа с ограниченным посещением больных (родильные дома). Наиболее значимы как источник инфекции лица с вяло протекающей патологией урогенитального тракта (пиелонефрит, цистит), кишечника (колиты, энтероколиты). Неравномерное созревание патологических фокусов создает трудности в выявлении источника инфекции. Необходимо многократное бактериологическое обследование с интервалом в 5-7 дней. Немаловажную роль играют лица с воспалительными поражениями кожи и подкожной клетчатки, лица с хронической патологией ЛОР-органов (тонзиллиты, бронхиты, ларингиты, риниты и др.)
Механизм, пути и факторы передачи: распространение ВБИ происходит как естественными, так и искусственным механизмами передачи.
К естественным механизмам при ВБИ относятся фекально-оральный, аспирационный, контактный, реже - трансмиссивный.
1. Фекально-оральному механизму соответствуют алимен
тарный (пищевой) и водный пути передачи. Водный путь реализует
ся крайне редко, только в тех ситуациях, когда имеет место терри
ториальное неблагополучие по качеству воды (аварийные ситуации
на водопроводных и канализационных сетях). Пищевой путь может
быть связан с пищеблоком ЛПУ - классические пищевые вспышки
возникающие при поступлении недоброкачественных продуктов
питания или в результате вторичного инфицирования (нарушение
технологических процессов). Передача алиментарный путем может
происходить и через жидкие лекарственные формы употребляемые
per os (физиологический раствор, раствор глюкозы, отвары трав и
другие препараты). :
2. Аспирационный механизм передачи с воздушно-
капельным и воздушно-пылевым путем передачи реализуется при
инфекциях вирусной и бактериальной природы, распространяю
щихся через воздух (грипп, ОРВИ, ветрянная оспа, дифтерия, рота-
вирусная инфекция, легионеллез и др.). Этому способствуют дефек
ты системы вентиляции и кондиционирования воздуха. Инфициро
ванный воздух с помощь так называемых "неорганизованных" по
токов может перемещаться по всему зданию с попаданием даже в
"стерильные" зоны (операционные). Заболевания могут быть связа
ны с вдыханием инфицированного водного или пылевого аэрозоля
при использовании аппаратов искусственного дыхания, наркозной
аппаратуры, увлажнителей кислорода (кислородные контуры), при физиотерапевтических процедурах (ингаляции).
3. Контактный механизм передачи с контактно-бытовым путем играет ведущею роль в распространении ВБИ, вызываемых гра-мотрицательными бактериями. Грамотрицательные микроорганизмы обладают способностью интенсивного размножения и накопления во влажных условиях (щетки для мытья рук, растворы дезин-фектантов при заниженной концентрации активного вещества, влажные полотенца для рук, ветошь и т.д.). Факторами перадачи являются руки медицинского персонала, медицинский инструментарий и аппаратура, перевязочный материал, белье, предметы ухода за больными и др.
Артифициальный (искусственный) механизм передачи реализуется при;
- инвазивных диагностических процедурах (забор крови, эн
доскопические исследования, пункции,зондирование, биопсии)
- инвазивных лечебных процедурах (инъекции, трансфузии,
оперативные вмешательства, интубация, катетеризация, трансплан
тация тканей и органов, иглоукалывание)
- неинвазивных лечебных процедурах (ингаляции, бальнео
логические процедуры, физиотерапевтические процедуры)
- неинвазивных диагностических процедурах (мануальное
обследование, стоматологическое обследование).
Характеристика эпидемического процесса: выраженной сезонности при ВБИ нет, заболевания и вспышки возникают на протяжении всего года и связаны с нарушениями санитарно-гигиенического и противоэпидемического режима.
Эпидемиологическое обследование очага: проводится с целью установления места инфицирования больного (занос, заражение в ЛПУ, отсутствие связи с ЛПУ); источника инфекции, путей и факторов передачи, границ очага, контактных.
Клиника: инкубационный период и клинические проявления будут зависить от этиологии ВБИ, места локализации воспалительного процесса, наличия одного или нескольких патологических фокусов, иммунного статуса и возраста больного, сопутствующих заболеваний.
Лабораторная диагностика: применяются бактериологические, вирусологические, паразитологические, серологические и мо-лекулярно-биологические методы диагностики. Расшифровка этиологической структуры ВБИ имеет важное значение для выбора ра-
циональных методов лечения, оценки эпидемиологической ситуации в стационаре и организации целенаправленных мероприятий. Для установления этиологического агента проводится:
- исследование патологического материала с количествен
ным определением микроорганизмов;
- идентификация и внутривидовое типирование;
- определение спектра чувствительности к антибиотикам,
химиопрепаратам;
- определение специфических антител в динамике в сыво
ротке крови
Поскольку большинство возбудителей ВБИ относятся к условно-патогенным микроорганизмам и часто являются представителями нормальной микрофлоры организма человека для подтверждения их роли как этиологического агента необходимо сочетание ряда признаков:
- выделение данного микроорганизма из патологического
фокуса в монокультуре или его доминирование в ассоциации
- массивность выделения (количественные методы)
- обнаружение данного микроорганизма при повторных ис
следованиях
- наличие специфических иммунологических сдвигов в ор
ганизме больного.
Лечение: после выявления возбудителя ВБИ проводится этиотропная терапия с учетом чувствительности к антибактериальным или химиопрепаратам. Применение антибиотиков с профилактической целью неоправданно, т.к. неизвестно разовьется или нет ВБИ у данного больного, и если оно возникнет, то какой этиологии будет. Следует соизмерять пользу от применения с риском возникновения токсических и аллергических реакций. Широкое и бесконтрольное применение антибактериальный препаратов привело к формированию резистентных штаммов, имеющих устойчивость к 15-20 антибитикам (P.aeruginosa). Профилактическое применение антибиотиков применяется при проведении хирургических операций относящихся к категории "загрязненных" (Ш группа). Перед или во время операции однократно вводится антимикробный препарат, обеспечивающий адекватную концентрацию в тканях. В послеоперационном периоде антибиотики не назначают. При "грязных" операциях (IV группа) с гнойно-воспалительными процессами антимикробные средства используются для лечения (с учетом чувствительности).
Меры борьбы и профилактики включают:
Организационные мероприятия: рациональная организация лечебного процесса (сокращение сроков пребывания больного в стационаре, назначение инвазивных процедур строго по показаниям); введение должности госпитального эпидемиолога в ЛПУ, основной функцией которого является проведение эпидемиологического надзора за ВБИ; создание комиссии по профилактике ВБИ в которую входят кроме врача эпидемиолога заместитель главного врача по лечебной части, главная (старшая) медицинская сестра, врач бактериолог или химиотерапевт и ряд других специалистов.
Паспортизация ЛПУ позволяет выявить недостатки материально-технической базы.
Важную роль в профилактике играют архитектурно-планировочные решения зданий. Размещение отделений по этажам, на одном этаже, разобщение "чистых" и "грязных" в отношении инфекций отделений.
В комплексе мер по нейтрализации источников инфекции необходимо предусмотреть ранее выявление инфекционной патологии у больных при поступлении в стационар (тщательный осмотр в приемном отделении на предмет выявления инфекционного заболевания) и во время пребывания в отделении (своевременный перевод или изоляция лиц с начальными проявлениями инфекции). Выявить больных среди медицинского персонала как с острыми, так и хроническими воспалительными процессами позволяет диспансеризация сотрудников. Последующее лечение очагов инфекции предотвратит заражение пациентов.
Для разрыва путей и факторов контактно-бытовой передачи необходимо соблюдать санитарно-гигиенический режим, включающий дезинфекционный режим, соблюдение правил личной гигиены, тщательную обработку рук медицинского персонала, использование одноразового инструментария, белья и др. Организация центральных стерилизационных отделений (ЦСО) позволяет обеспечить ЛПУ стерильным инструментарием, бельем, перевязочным материалом.
Для прерывания воздушно-капельной (воздушно-пылевой) передачи необходимо контролировать работу вентиляционной системы, кондиционеров, увлажнителей. Использование ламинарных установок обеспечивает подачу стерильного воздуха; общую микробную обсемененность воздуха удается снизить при использовании переносных рециркуляционных воздухоочистителей.
Контроль за соблюдением санитарно-гигиенического режима на пищеблоке позволяет предупредить пищевые вспышки в ЛПУ. Современные аптечные линии, централизованная поставка стерильных лекарственных растворов предупреждает передачу инфекции пищевым путем (через жидкие лекарственные формы).
Для предупреждения профессиональных случаев заражения медицинского персонала проводят вакцинацию против инфекций, занос и распространение которых наиболее часто встречается в разных типах стационаров (гепатиты В, А, дифтерия, корь, краснуха и др.). Обследование медицинских работников на ряд инфекций предусмотрено нормативными документами (ВИЧ-инфекция, ИППП, гепатиты В Си др.). В связи с неблагоприятной эпидемической ситуацией и высокой вероятностью заноса в стационар нужно обследовать медицинский персонал на туберкулез с помощью реакции Манту.
Серьезное внимание должно уделяться профессиональной подготовке сотрудников ЛПУ по вопросам эпидемиологии и профилактики ВБИ.
Соблюдение мер личной безопасности при контакте с кровью и выделениями больных, при работе с колюще-режущими инструментами, использование перчаток, масок, пластиковых экранов и других средств индивидуальной защиты для предотвращения попадания заразного материала на кожу и слизистые оболочки медицинских работников позволяет предупредить профессиональные случаи заражения.
Поскольку большинство ВБИ вызываются условно-патогенными микроорганизмами, при которых основную роль играет иммунный статус человека лицам относящимся к группам риска целесообразно назначать препараты повышающие состояние неспецифических защитных сил организма.
Тема 2.1. Внутрибольничная инфекция.
Инфекционный контроль - система эффективных организационных, профилактических и противоэпидемических мероприятий, направленных на предупреждение возникновения и распространения инфекционных заболеваний в стационаре, базирующихся на результатах эпидемиологической диагностики.
Госпитальные инфекции - любые инфекционные заболевания (состояния), проявившиеся или возникшие в условиях стационара. Понятие ГИ включает в себя заносы инфекции и внутрибольничные инфекции.
Заносы инфекции - это инфекционные заболевания, с местом заражения вне лечебно-профилактического учреждения, но проявившиеся при поступлении в стационар, либо во время пребывания в стационаре.
Внутрибольничные (нозокомиальные) инфекции (ВБИ) это инфекционные заболевания (состояния), возникшие в данном лечебном учреждении и не имевшиеся до поступления в стационар даже в инкубационном периоде, проявившиеся в условиях стационара или после выписки пациента в течение инкубационного периода. Либо связанные с проведением медицинских манипуляций в амбулаторно-поликлинических условиях.
Примечание: инфекции, вызванные условно-патогенными микроорганизмами, могут считаться внутрибольничными в пределах 30 дней после выписки из стационара, если установлен факт внутрибольничного заражения. К внутрибольничным инфекциям относятся также случаи инфицирования работников лечебно-профилактических учреждений, возникшие в результате их профессиональной деятельности. Внутрибольничные инфекции представляют собой одну из важнейших проблем медицинских учреждений.
Исследования в разных странах мира показывают: внутрибольничная инфекция - одно из наиболее частых осложнений в период госпитализации.
Эффективность инфекционного контроля зависит от всех работников системы здравоохранения. Для успеха программ инфекционного контроля на уровне больниц важно взаимопонимание между больничными эпидемиологами, другими специалистами по инфекционному контролю, микробиологами, врачами-клиницистами, медицинскими сестрами и администрацией.
Все работники здравоохранения должны знать и применять основные меры предупреждения инфекционных заболеваний. Однако в силу своих профессиональных обязанностей медицинские сестры имеют более тесный контакт с пациентами. Поэтому именно им отводится лидирующая роль в применении принципов инфекционного контроля в лечебных заведениях.
Особенностью внутрибольничных инфекций является то, что они могут вызываться не только облигатными патогенами, но и оппортунистическими возбудителями со сравнительно невысокой патогенностью, особенно у больных с тяжелым течением патологического процесса.
Заболевания ВБИ обычно вызваны внутригоспитальными штаммами условно-патогенных грамположительных и грамотрицательных бактерий, отличающихся по своей биологической характеристике от внегоспитальных штаммов и обладающих множественной лекарственной резистентностью, более высокой устойчивостью по отношению к неблагоприятным факторам окружающей среды - высушиванию, действию ультрафиолетовых лучей, дезинфицирующих препаратов. При заниженных концентрациях дезинфектантов внутрибольничные штаммы могут не только сохраняться, но и размножаться в них.
Взаимодействие организма хозяина, микроорганизма и окружающей среды составляют основу эпидемиологии инфекционных болезней. Когда речь идет о внутрибольничных инфекциях, вероятность развития инфекций определяет взаимодействия между человеком (госпитализированным пациентом или медицинским работником), возбудителями внутрибольничной инфекции и больничным окружением, включающим, прежде всего, различные лечебные и диагностические процедуры.
Эпидемиологический процесс можно рассматривать в виде цепочки, состоящей из трех звеньев. Чтобы инфекция возникла, должны присутствовать все три звена - возбудитель, средство передачи и вероятный объект попадания, то есть восприимчивый к инфекциям организм человека.
Первое звено в цепи инфекции - возбудители инфекции. К ним относятся:
Возбудители внутрибольничной инфекции варьируют по своей структуре и размерам. Наибольшее значение в качестве возбудителей внутрибольничной инфекции имеют бактерии, некоторые вирусы и грибы.
Для успешной передачи возбудителей восприимчивому организму хозяина необходимо сохранение жизнеспособности микроорганизма в окружающей среде, из которой позже может произойти его передача.
Резервуары, где происходят развитие и размножение внутрибольничных микроорганизмов, могут быть как одушевленными (например, медицинские работники в случае стафилококковой инфекции), так и неодушевленными (например, увлажнители воздуха в случае легионеллеза).
При попадании в организм хозяина микроорганизмы не обязательно вызывают инфекцию. Они могут существовать и размножаться, не повреждая при этом ткани и не вызывая иммунного ответа у хозяина (это состояние называется колонизацией).
Способность микроорганизма вызывать инфекцию и тяжесть течения заболевания зависит от ряда внутренних характеристик микроорганизма.
Способы передачи инфекций
Второе звено в цепочку инфекций - средство передачи. Почти все внутрибольничные инфекционные заболевания могут быть сгруппированы в три основные категории в зависимости от путей передачи, а именно: заболевания, передающиеся контактным путем; заболевания, передающиеся капельным (воздушно-капельным) путем; заболевания, передающиеся воздушным (воздушно-пылевым) путем. Пищевой, водный, трансмиссивный пути передачи, а также вертикальный механизм передачи мало значимы применительно к внутрибольничным инфекциям и не являются центром внимания программ инфекционного контроля в больницах США. Однако эти пути передачи по-прежнему достаточно актуальны в стационарах СНГ, где довольно часто регистрируются вспышки, связанные с реализацией пищевого и водного путей передачи.
Возбудители инфекций могут передаваться:
§ через прямой контакт человека с человеком, такой, как непосредственный контакт медицинского персонала с пациентами или с их секретами, экскретами и другими жидкими выделениями человеческого организма;
§ при непрямом контакте пациента или медицинского работника с загрязненным промежуточным предметом, включая загрязненное оборудование или медицинские принадлежности;
§ через капельный контакт, имеющий место при разговоре, чихании или кашле;
§ при распространении по воздуху возбудителей инфекции, содержащихся в капельных молекулах, частицах пыли или взвешенных в воздухе, проходящем через вентиляционные системы;
§ через обычные средства, поставляемые в медицинские учреждения: загрязненная кровь, лекарства, пища или вода. Микроорганизмы могут размножаться на этих поступающих в больницу средствах, а могут - и нет;
§ через переносчика инфекции. Инфекция может передаваться от человека человеку через животное или насекомое, играющее роль промежуточного хозяина или переносчика заболевания.
Контакт - самое распространенное средство передачи инфекции в современных больницах.
Наиболее распространенные инфекционные заболевания и способы их передачи:
§ ветряная оспа прямой, непрямой или капельный контакт
§ коревая краснуха капельный контакт
§ гепатит В прямой или непрямой контакт
§ краснуха капельный контакт
§ туберкулез воздушный, капельный контакт
§ СПИД прямой контакт (кровь или жидкие выделения)
§ малярия переносчики инфекции
§ желтая лихорадка переносчики инфекции
Восприимчивым называется человек, у которого сопротивляемость определенному патогенному агенту недостаточно эффективна. Развитие инфекции и тяжесть клинических проявлений зависят не только от свойств возбудителя, но и от некоторых факторов, присущих организму хозяина:
§ генетически обусловленный иммунный статус
§ генетически обусловленная неспецифическая резистентность
§ наличие иммунодефицита, приобретенного вследствие заболевания или терапии
Восприимчивость человеческого организма к инфекциям увеличивается при:
§ наличие открытых ран;
§ наличие инвазивных устройств, таких, как внутрисосудистые катетеры, трахеостомы и т.д.;
§ наличии основного хронического заболевания, такого, как сахарный диабет, иммунодефицит, неоплазмоз, лейкемия;
§ определенном терапевтическом вмешательстве, включающем иммуноподавляющую терапию, облучение или антибиотики.
Вся совокупность госпитальных условий приводит к тому, что наряду с возможным возникновением и распространением инфекционных заболеваний, которые встречаются вне стационаров, для госпитализированных пациентов характерны заболевания, вызываемые условно-патогенными микроорганизмами.
В ряде случаев, особенно в стационарах хирургического профиля, условно-патогенные микроорганизмы доминируют в качестве возбудителей заболеваний.
Развитие инфекций, вызываемых условно-патогенными микроорганизмами в госпитальных условиях, возможно при наличии одного из четырех условий:
§ заражение очень большой дозой микроорганизмов одного штамма
§ ослабление организма пациента
§ усиление вирулентности этиологического агента
§ необычные, эволюционно не обусловленные входные ворота и поражение соответствующих тканей, вегетация на которых не обеспечивает сохранения возбудителя как биологического вида.
Необходимо ответить, что чаще имеет место действие не одного, а сразу нескольких упомянутых факторов, приводящих к развитию заболеваний, вызываемых условно-патогенными микроорганизмами.
Как разрушить цепочку инфекций
Если прервать цепочку инфекции в любом из трех вышеприведенных звеньев, эпидемический процесс можно остановить. У медицинского персонала имеется несколько способов разрушить цепочку инфекции, воздействуя на возбудитель, путь передачи и/или восприимчивость (иммунитет) организма человека. Комплексные эпидемиологические мероприятия должны быть направлены на все три звена.
Способы профилактики инфекции
Самые важные способы снижения риска переноса инфекции в лечебном учреждении следующие:
§ добросовестность выполнения персоналом всех требований, относящихся к гигиене, мытью рук и использованию защитной одежды
§ тщательное соблюдение всех приемов ухода за пациентом, что сводит до минимума распространение возбудителей инфекции
§ использование методов санитарии, направленных на уменьшение числа возбудителей инфекции, имеющихся в больнице.
Вопросы для самоконтроля
1. Дайте определение понятию «Инфекционный контроль».
2. Дайте определение понятию «Госпитальные инфекции».
3. Дайте определение понятию «Внутрибольничные (нозокомиальные) инфекции».
4. Охарактеризуйте цепочку инфекционного процесса.
5. Назовите механизмы передачи инфекции.
6. Перечислите способы передачи инфекции.
7. Перечислите пути передачи инфекции.
8. Перечислите факторы, способствующие распространению инфекции.
9. Назовите, что способствует восприимчивости человека к инфекции.
10. Расскажите, как можно разрушить цепочку инфекционного процесса.
11. Перечислите способы профилактики инфекции.
Литература
1.Мухина С.А. Тарновская И.И. Теоретические основы сестринского дела: Учебник. - 2-е изд., испр. и доп. - М.: ГЭОТАР - Медиа, 2008.
2.Мухина С. А. , Тарновская И. И. «Практическое руководство к предмету «Основы сестринского дела» Москва Издательская группа «Гэотар-Медиа» 2008.
3.Обуховец Т.П., Склярова Т.А., Чернова О.В. Основы сестринского дела. - Ростов е/д.: Феникс, 2002. - (Медицина для вас).
4.Основы сестринского дела: введение в предмет, сестринский процесс. ∕Составитель С.Е. Хвощёва. - М.: ГОУ ВУНМЦ по непрерывному медицинскому и фармацевтическому образованию, 2001.
5.Островская И.В., Широкова Н.В. Основы сестринского дела: Учебник. - М.: ГЭОТАР - Медиа, 2008.
Дополнительная:
СанПиН 2.1.3.2630-10 "Санитарно-эпидемиологические требования к организациям, осуществляющим медицинскую деятельность".
Рекомендуем для прочтения:
Сравнительно-сопоставительный анализ реформ Александра II и контрреформ Александра III Таблица 3 Александр II (1855 - 1881 гг.) Александр III (1881 - 1894.
Типовые задачи с решениями № 1. На рынке совершенной конкуренции установилось равновесие при спросе QD = 150 &ndash.
Понятие «общественное здание». Классификация общественных зданий по различным признакам Общественные здания - общее определение зданий и помещений.
Значение психологических знаний для учителя Приступая к педагогической работе с детьми, педагогу нужно разобраться в том, что ребёнку дано от природы (является врожденным) и что.
Алгоритм измерения массы тела пациента (взрослого) Медицинский работник должен обязательно предупреждать пациента о необходимости опорожнения мочевого пузыря и кишечника до момента.



Тьма не может изгнать тьму; только свет может сделать это. Ненависть не может изгнать ненависть; только любовь может сделать это. © Лютер Кинг ==> читать все изречения.
Читайте также:
